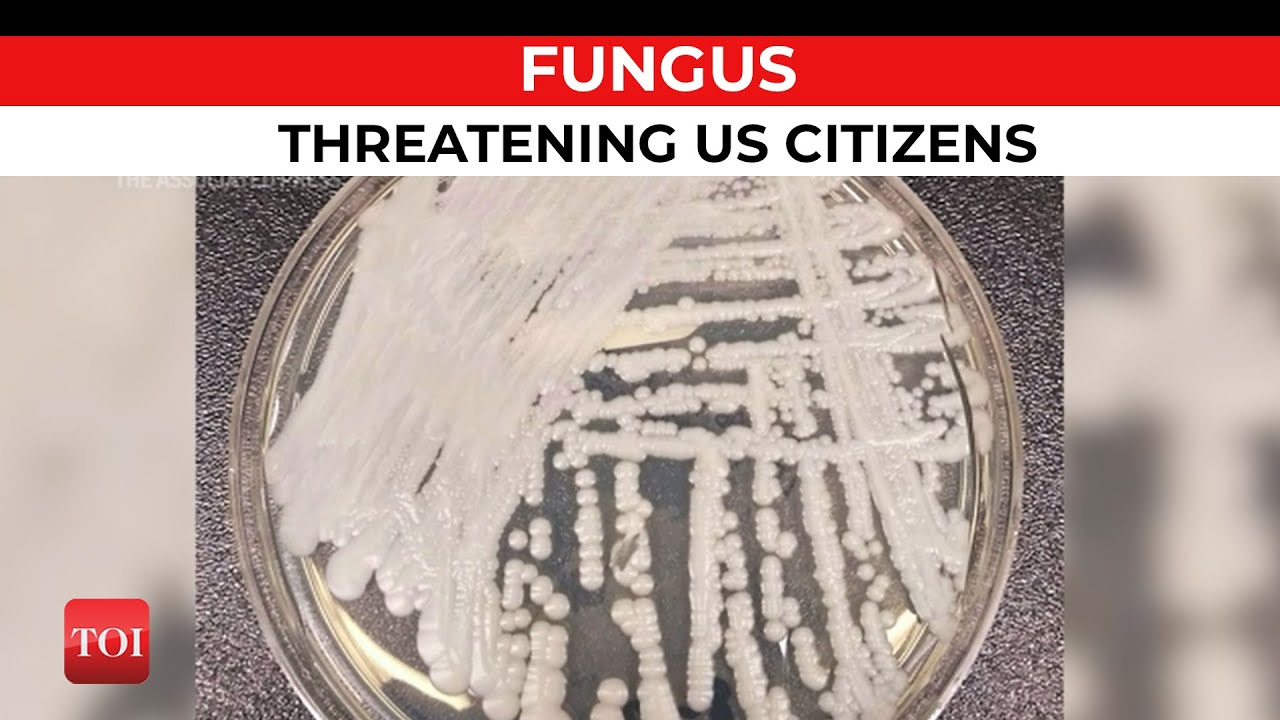

Candida auris

Boosted Surveillance Infection Control Swiftly Contained Super Bug Physician S Weekly

1gcvy9fnwazwzm

Hpbnqtj5e0cb4m

0ixhwtsdv0i Sm

Qz9vmerstoy10m

Candida Auris A Pathogen Difficult To Identify Treat And Eradicate And Its Characteristics In Japanese Strains Sciencedirect

New Medical Worry A Deadly Fungal Infection That Resists Treatment Goats And Soda Npr

Candida Auris Infection And Biofilm Formation Going Beyond The Surface Springerlink

Something Wicked This Way Comes What Health Care Providers Need To Know About Candida Auris Ccdr 2018 44 11 Canada Ca

Candida Auris Infection

Jof Free Full Text Melanization Of Candida Auris Is Associated With Alteration Of Extracellular Ph

Explainer What Is Candida Auris And Who Is At Risk

Agvjqqzh92ptjm

Zduz9 Krvduopm

L 2b6u5eftn2em

Candida Auris A Drug Resistant Germ That Spreads In Healthcare Facilities Candida Auris Fungal Diseases Cdc

Candida Auris Ohio Department Of Health

Fungiplex Candida Auris Ruo Bruker